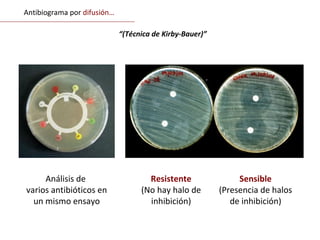
Resistente
(No hay halo de
inhibición)
Análisis de
varios antibióticos en
un mismo ensayo
Sensible
(Presencia de halos
de inhibición)
Antibiograma por difusión…
“(Técnica de Kirby-Bauer)”
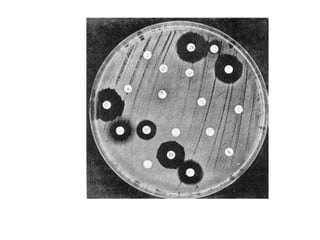

Este documento describe varios conceptos relacionados con agentes antimicrobianos. Explica que la esterilización elimina todos los microorganismos vivos, mientras que la desinfección elimina solo los que causan enfermedades. Luego describe diferentes agentes físicos, químicos y antimicrobianos, así como factores que afectan su actividad contra los microorganismos. Finalmente, discute las diferencias entre evaluar la susceptibilidad a antimicrobianos in vitro e in vivo.